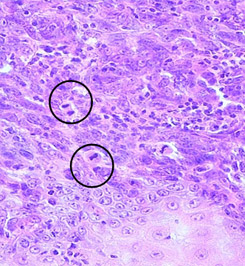
Оценка митотического индекса

ВЕСТНИК МОСКОВСКОГО ОНКОЛОГИЧЕСКОГО ОБЩЕСТВА
Informo, ergo sum!
Московского
Онкологического
Общества
ПРЕДЛОЖЕНИЕ, ОТ КОТОРОГО НЕ СМОЖЕТ ОТКАЗАТЬСЯ СОВМЕСТНОЕ ЗАСЕДАНИЕ ОНКОЛОГОВ И ПАТОЛОГОАНАТОМОВ:
ОБСУДИТЬ ЗНАЧЕНИЕ ХАРАКТЕРИСТИК
МОРФОЛОГИЧЕСКОГО ДИАГНОЗА
ДЛЯ КЛИНИЧЕСКОЙ ПРАКТИКИ…
| №9 (580) 2011 ОКТЯБРЬ |
ЗАСЕДАНИЕ 580
посвященное памяти академика Н.А. Краевского,
совместное с Российским обществом патологоанатомов
состоится во вторник 11 октября 2011 г. в 17:00
в конференц-зале Российского онкологического
научного центра им. Н.Н. Блохина
Президиум: проф. А.И. Пачес, академик РАМН, проф. Ю.Н. Соловьев, чл.-корр. РАМН, проф. Г.А. Франк, проф. Л.В. Демидов
Повестка дня:
ДИАГНОСТИКА и ЛЕЧЕНИЕ МЕЛАНОМЫ
Доклад:
СОВРЕМЕННАЯ МОРФОЛОГИЧЕСКАЯ, ИММУНОГИСТОХИМИЧЕСКАЯ И МОЛЕКУЛЯРНО-ГЕНЕТИЧЕСКАЯ ДИАГНОСТИКА МЕЛАНОМЫ КОЖИ
Вишневская Я.В., Машенкина Я.А., Сендерович А.И.,
Строганова А.М., Полуэктова Ю.В.
(отдел патологической анатомии опухолей человека
РОНЦ им. Н.Н. Блохина)
Доклад:
НОВЫЕ НАПРАВЛЕНИЯ В ЛЕЧЕНИИ БОЛЬНЫХ МЕЛАНОМОЙ КОЖИ
Демидов Л.В., Харкевич Г.Ю., Михайлова И.Н.,
Петенко И.Н., Самойленко И.В., Утяшев И.А.
(отделение биотерапии РОНЦ им. Н.Н. Блохина)
Дискуссия:
ЗНАЧЕНИЕ МОРФОЛОГИЧЕСКОГО ДИАГНОЗА МЕЛАНОМЫ ДЛЯ КЛИНИЧЕСКОЙ ПРАКТИКИ
ПРОГНОСТИЧЕСКАЯ ОЦЕНКА ДИСПЛАСТИЧЕСКОГО НЕВУСА, ЛИМФОИДНОЙ ИНФИЛЬТРАЦИИ, МИТОТИЧЕСКОГО ИНДЕКСА, ДЕСМОПЛАЗИИ (НЕЙРОТРОПИЗМА) И ДРУГИХ МОРФОЛОГИЧЕСКИХ ХАРАКТЕРИСТИК
Мониторинг общественной жизни
МОНО- и МУЛЬТИДИСЦИПЛИНАРНЫЕ
ОНКОЛОГИЧЕСКИЕ СООБЩЕСТВА
В общественной жизни онкологов нарастают прогрессивные изменения. Одно за другим возникают, проводят научно-практические форумы и начинают процветать различные профессиональные онкологические сообщества – урологов, колопроктологов, гинекологов, химиотерапевтов, специалистов в онкологии области головы и шеи, и др.
Московское онкологическое общество, несомненно, поддерживает стремление профессионалов решать свои профессиональные вопросы в узком профессиональном кругу! А что касается собственных перспектив то Московское онкологическое общество с оптимизмом смотрит в свое светлое будущее. И вот почему.
Московское онкологическое общество сложилось как мультидисциплинарная организация. Общество стремится обсуждать вопросы, касающиеся онкологов различных специализаций, причем не только онкологов. В недавних повестках дня – совместные заседания онкологов и хирургов, онкологов и терапевтов, онкологов и специалистов по социальной гигиене. На заседаниях обсуждаются результаты обследования и лечения, полученные различными, в том числе альтернативными методами. Успехи, достигнутые в одной из узких областей могут безотлагательно стать востребованными и найти широкое применение в других сферах онкологической практики.
Показательна тематика заседаний хотя бы текущего года. Обсуждение операций в объеме одномоментной эзофагогастрэктомии (январь, 2011 г.) привлекло внимание торакальных и абдоминальных хирургов. Разработка оптимальных путей совершенствования высокодозной химиотерапии объединило за общим круглым столом в феврале гематологов и реаниматологов. Гипертермическая интраоперационная химиотерапия (в марте) затронула интересы хирургов, химиотерапевтов, онкоколопроктологов, онкогинекологов…
МУЛЬТИДИСЦИПЛИНАРНОСТЬ МОСКОВСКОГО
ОНКОЛОГИЧЕСКОГО ОБЩЕСТВА
Эндопротезирование при опухолях костей и суставов (в апреле), как минимум, коснулось онкологов и ортопедов. Предстоящее (в ноябре 2011 г.) обсуждение проблем раннего рака и других опухолей желудка не должно остаться без внимания хирургов, специалистов по эндоскопической мукозэктомии и фотодинамической терапии.
Наконец, традиционное ежегодное совместное заседание онкологов и патолоанатомов памяти академика Н.А. Краевского также предлагает рассмотрение актуальных общих вопросов, что специально указано в повестке дня. Обсуждение характеристик морфологического диагноза меланомы, их значений для клинической практики может (и должно) стать кульминационным моментом совместных усилий морфологов и онкологов.
Общество мультидисциплинарно. И, как отметил бы литературный классик: «Тем (оно) и интересно».
Организационный комитет
Московского онкологического общества
Постскриптум. Московское онкологическое общество начинает сбор членских взносов на 2011-2012 производственный год. С начала 2000-х гг. взнос в 100 рублей выплачивают стажеры, ординаторы, аспиранты; 300 рублей в год – это взнос дипломированных онкологов, а 500 – онкологов-руководителей.
В клинических подразделениях НИИ клинической онкологии РОНЦ им. Н.Н. Блохина выплаты дифференцированы от 100 (взнос обучаемых специалистов) до 1000 рублей (взнос профессоров и руководителей отделений). Особую ауру кампании сбора взносов определяют следующие положения: 1) Специалисты, вступившие в Общество в 1950–1960-х гг. взносов больше не платят. 2) Специалисты, состоящие в иных профессиональных сообществах (анестезиологи, реаниматологи, рентгенологи, др.), имеют безусловное право на скидки. 3) Взнос может быть выплачен передачей Обществу части тиража научной продукции (книг, периодических изданий, видеофильмов…)
ТРУДЫ МОСКОВСКОГО ОНКОЛОГИЧЕСКОГО ОБЩЕСТВА
Рефераты сообщений:
PROCEEDINGS OF THE MOSCOW CANCER SOCIETY #580
(October 11, 2011)
The Proceedings is held jointly with the society of Pathologists
to honor the memory of Prof. N.A.KRAEVSKY (1905-1985)
THE PROGRESS IN DIAGNOSTIC PROCEDURES AND MANAGEMENT OF SKIN MELANOMA
Report 1: CURRENT STATUS IN PATHOLOGY, IMMUNOHISTOCHEMISTRY, MOLECULAR-GENETIC ASPECTS OF MELANOMA. By Prof. Ja. Vishnevskaya et al. (The N.N. Blokhin Russian Cancer Research Center’ Dept. of Pathology).
Report 2: NEW APPROACHES IN THE TREATMENT OF SKIN MELANOMA. By Prof. L. Demidov, Dr. Kharkevich, et al. (The N.N. Blokhin Russian Cancer Research Center’ Dept. of Biotherapy).
Доклад:
СОВРЕМЕННАЯ МОРФОЛОГИЧЕСКАЯ, ИММУНОГИСТОХИМИЧЕСКАЯ И МОЛЕКУЛЯРНО-ГЕНЕТИЧЕСКАЯ ДИАГНОСТИКА МЕЛАНОМЫ КОЖИ
Вишневская Я.В., Машенкина Я.А., Сендерович А.И.,
Строганова А.М., Полуэктова Ю.В.
(отдел патологической анатомии опухолей человека
РОНЦ им. Н.Н. Блохина)
Меланома кожи – злокачественная опухоль из клеток меланоцитарной системы – характеризуется как заболевание с агрессивным клиническим течением, значительным метастатическим потенциалом, неблагоприятным прогнозом. Современные эпидемиологические исследования показали стремительный рост заболеваемости меланомой в разных странах, в том числе и в Российской Федерации, где за 2000-е гг. она выросла в 1,5 раза, составив 42,6 на 100.000 населения – ежегодно в РФ заболевают свыше 7700, а умирают – более 3000 пациентов [1]. При этом, в 2000-х гг. несмотря на рост заболеваемости отмечена тенденция к замедлению роста смертности, уменьшению числа больных IV стадией процесса. Если в 1998 г. этот показатель составлял 33,8%, то к 2008 г. он снизился до 29,2% [2]. Изменения статистики связываются с совершенствованием диагностики меланомы, внедрением в морфологическую практику иммуногистохимических и молекулярно-генетических исследований [3-6].
Гистологическое исследование меланомы предусматривает определение параметров, влияющих на клиническое течение («biologic behaviour») меланомы и прогноз заболевания: форма роста, гистологический вариант, наличие/отсутствие пигмента, толщина опухоли по Бреслоу (A.Breslow, 1970), уровень инвазии по Кларку (W.Clark, 1967), а также таких характеристик как наличие изъязвления, митотический индекс, сосудистая (ангиолимфатическая) инвазия, выраженность лимфоидной инфильтрации, проявления спонтанной регрессии, наличие сателлитов*), транзитных**) (и других) метастазов. При гистологическом исследовании также оценивается наличие/отсутствие элементов опухоли по краю удаленного фрагмента кожи.
Наиболее важными факторами прогноза являются толщина опухоли по Бреслоу и изъязвление; для опухолей толщиной менее 1,0 мм учитываются уровень инвазии по Кларку и митотический индекс (рис. 1).
Толщина опухоли по Бреслоу измеряется в миллиметрах с помощью оптического микрометра. При этом учитывается уровень инвазии по Кларку и максимальная толщина опухолевого узла. Изъязвлением считается отсутствие эпидермиса над опухолью. При этом определяются поверхностные грануляции, зоны некроза, фиброзно-лейкоцитарные наложения (эрозирование поверхности с сохранением части слоев эпидермиса не является изъязвлением). Митотический индекс оценивается по максимальному количеству митозов в 1 мм2.
![]() | ![]() |
| А) | Б) |
![]() | ![]() |
| В) | Г) |
Рис. 1. Наиболее важные морфологические факторы прогноза.
А) Схема определения уровня инвазии по Кларку (W.Clark, 1967);
Б) Схема определения толщины опухоли по Бреслоу (A.Breslow, 1970);
В) Гистологическая картина изъязвления;
Г) Оценка митотического индекса.
*) Сателлиты – очаговые скопления клеток меланомы диаметром более 0,05 мм, четко отграниченные от основного инвазивного компонента меланомы нормальной дермой или клетчаткой и расположенные от первичной опухоли на расстоянии не менее 0,3 мм.
**) Транзитные метастазы – опухолевые узлы любого размера, расположенные в коже на расстоянии более 2 см от первичной опухоли.
Точное определение гистологических характеристик удаленной опухоли является ключевым фактором в определении прогноза и планировании дополнительного лечения. Поэтому стадирование меланомы кожи по ТNМ не выполняется дооперационно; оно возможно лишь после полного гистологического исследования удаленного препарата.
Стадирование меланомы (версия American Joint Committee on Cancer – AJCC):
Критерий Т определяется по толщине по Бреслоу, наличию/отсутствию изъязвления, уровеню инвазии по Кларку (при толщине опухоли до 1 мм).
Критерий N определяется по наличию/отсутствию пораженных лимфоузлов, сателлитов и транзитных метастазов.
Критерий M отражает наличие/отсутствие отдаленных метастазов, а также уровень ЛДГ в сыворотке крови.
Иммуногистохмическое исследование меланомы позволяет уточнить диагноз, в том числе провести дифференциальную диагностику с другими меланоцитарными новообразованиями, выявить микрометастазы. Иммуногистохимическое исследование проводится с использованием моно- и поликлональных антител. В меланоцитарных опухолевых клетках экспрессируется Vimentin, протеин S100(A4), а также специфические меланоцитарные маркеры PanMelanoma, Мelan-A, Melanosome, MITF-M, Tyrosinasa и др. К прогностическим маркерам меланомы относятся p53, Ki67, белки теплового шока, bcl 2, VLA, a-v/b-3 интегрины, CD 26, NM 23, E-кадхерин, циклин D1, циклин D3, p16-INK-4a, фактор VIII, CD 31, CD 34, подопланин, С-kit (CD117).
Молекулярно-генетическая диагностика меланоцитарных поражений кожи необходима в сложных случаях, для дифференциальной диагностики злокачественных и доброкачественных пигментных опухолей и опухолей иного гистогенеза. Генетические нарушения выявляются по результатам FISH-исследования (Fluorescent In Situ Hibridization).
FISH-исследование определяет состояние генов RREB1(6p25), MYB(6q23), CCND1(11q13), CEP6. Меланома характеризуется следующими параметрами: среднее количество гена CCND1 на ядро ≥2,5; частота ядер с «ненормальным» количеством гена RREB1 (т.е. ядра с сигналами RREB1 более или менее 2) ≥63%; частота ядер с потерей гена MYB относительно CEP6 ≥31%; среднее количество гена MYB на ядро ≥2,5. Генетические нарушения выявляются как на ранней стадии формирования опухоли, в фазе радиального роста, так и на более поздней – в фазе вертикального роста.
Важным результатом молекулярно-генетических исследований стало выявление меланом с преобладающим типом нарушений. Так, было установлено, что не менее чем у 50% больных меланомой обнаруживается мутация гена BRAF V600E. В норме ген BRAF регулирует рост клеток, но при данной мутации он начинает способствовать диссеминации клеток меланомы. Это обстоятельство стало основой для разработки таргетного препарата вемурафениб (zelboraf ™) который блокирует экспрессию мутировавшего гена BRAF V600E, что способствует успеху лекарственной терапии.
Литература
- Давыдов М.И., Аксель Е.М. Смертность населения России и стран СНГ от злокачественных новообразований в 2007 г. // Вестник РОНЦ им.Н.Н. Блохина. – Приложение 1. – 2009. – Т. 20, №3, С. 93.
- Чиссов В.И., Старинский В.В., Петрова Г.В. Состояние онкологической помощи населению России в 2008 г. // М., 2009. – С. 192.
- Демидов Л.В., Соколов Д.В., Булычева И.В. Совершенствование методов диагностики меланомы кожи // Вестник РОНЦ им. Н.Н. Блохина. – 2007. – Т.18, №1. – С. 36-41.
- Демидов Л.В., Харкувич Г.Ю,, Маркина И.Г. Меланома и другие злокачественные новообразования кожи (глава в книге: Энциклопедия клинической онкологии. Под ред. М.И.Давыдова). М., 2004. – С. 341-364.
- Сендерович А.И., Строганова А.М., Карселадзе А.И. Молекулярно-генетические нарушения меланоцитарных поражений человека. // Вестник РОНЦ им. Н.Н.Блохина. – 2010. – Т. 21, № 2. – С. 19-28.
- Balch C.M., Soong S.J., Gershenwald J.E., Thompson J.F., Reintgen D.S., et al. Prognostic factors analysis of 17600 melanoma patients: validation of the American Joint Committee on Cancer melanoma staging system. – J Clin Oncol., №19. – 2001. – Р. 3622-3634.
Доклад:
НОВЫЕ НАПРАВЛЕНИЯ В ЛЕЧЕНИИ БОЛЬНЫХ МЕЛАНОМОЙ КОЖИ
Демидов Л.В., Харкевич Г.Ю., Михайлова И.Н.,
Петенко И.Н., Самойленко И.В., Утяшев И.А.
(отделение биотерапии РОНЦ им. Н.Н. Блохина)
Интерес онкологов к проблемам лечения больных меланомой кожи возрастает вместе с ростом заболеваемости и смертности. Согласно данным статистики в 1990–2000-х гг. заболеваемость в РФ увеличилась на 59% для мужчин и на 64% – для женщин. Темпы прироста смертности в 2000-е гг. составили 42% у мужчин и 18% – у женщин. Опыт стран с высоким уровнем заболеваемости свидетельствует о том, что внедрение системы ранней диагностики позволяет повысить 5-летнюю выживаемость при меланоме I-II стадии до 90%. Напротив, прогноз метастатической меланомы остается крайне неблагоприятным – средняя продолжительность жизни составляет 6-8 месяцев. Стандартом лечения в таких случаях считается химиотерапия (дакарбазин), в том числе в сочетании с биологически активными препаратами (цитокины). Однако, несмотря на повышение частоты лечебных эффектов по результатам клинических исследований, это не привело к увеличению общей продолжительности жизни.
Прогресс в лечении больных метастатической меланомой связывается с применением таргетных препаратов – при таргетной иммунотерапии (ипилимумаб), в результате блока экспрессии мутировавшего гена BRAF V600E ингибитором BRAF (вемурафениб; zelboraf ™), а также – применением вакцин из дендритных клеток.
ТАРГЕТНАЯ (МОЛЕКУЛЯРНО-НАЦЕЛЕННАЯ) ИММУНОТЕРАПИЯ проводится препаратом ипилимумаб – моноклональными антителами против антигена-4 цитотоксических Т-лимфоцитов (CTLA-4). Это препарат способный «управлять» противоопухолевым иммунитетом. Он не оказывает непосредственного воздействия на опухоль, а действует на звенья иммунной системы. Антитела к CTLA-4, как и Т-клеточные рецепторы, являются естественно возникшими регуляторами иммунного ответа. Блокада рецептора CTLA-4 может увеличивать противоопухолевую активность Т-клеток (рис.).
Эффективность нового лекарственного средства показана в клинических исследованиях при метастатической меланоме кожи. Результаты рандомизированного исследования III фазы MDX010-20 (2004-2008 гг.) вызвали огромный интерес. Исследование проведено среди 676 больных, которые были рандомизированы в 3 группы при соотношении 3:1:1. В первой группе применены импилмумаб + вакцина gp100, во второй – вакцина gp100 + плацебо и в третьей группе – ипилимумаб + плацебо. Ипилимумаб достоверно увеличивал общую выживаемость. Ее медиана в анализированных группах составила 10,0; 6,4 и 10,1 мес (эффект препарата не усиливался при добавлении вакцины).

Рис. Механизм действия ипилимумаба (сценарии развития иммунного ответа).
1- схема слева) Успешный иммунный ответ. Цитотоксический Т-лимфоцит (вверху) взаимодействует с антигенпрезентирующей клеткой (внизу). Взаимодействие происходит одновременно через две системы, передачей соответствующих сигналов. ПЕРВЫЙ СИГНАЛ: Т-клеточный рецептор (ТСR) лимфоцита распознает комплекс: антиген + главный комплекс гистосовместимости (МНС) на антигенпрезентирующей клетке. ВТОРОЙ – АКТИВИРУЮЩИЙ – СИГНАЛ: ко-стимуляторная молекула В7 на Т-клеточном рецепторе связывается с молекулой СD28 на Т-лимфоците. В результате ко-стимуляции через СD28 происходит активация Т-клетки.
2- схема в центре) Развитие иммунной толерантности. ТСR лимфоцита распознает комплекс МНС на антигенпрезентирующей клетке (ПЕРВЫЙ СИГНАЛ), но ко-стимуляторная молекула В7 на Т-клеточном рецепторе связывается не с молекулой СD28 на Т-лимфоците, а с CTLA-4. (ВТОРОЙ – ТОРМОЗНОЙ – СИГНАЛ). Молекулы CD28 и CTLA-4, находящиеся на лимфоцитах, конкурируют за связывание с В7. Активации Т-клетки не происходит. Развивается иммунологическая толерантность.
3- схема справа) Фармакологическая блокада CTLA-4 моноклональными антителами (препарат ипилимумаб) приводит к тому, что ко-стимуляторная молекула В7 на Т-клеточном рецепторе может связываться только с молекулой СD28 на Т-лимфоците. В результате происходит активация Т-клетки и развивается иммунологический ответ.
В 2011 году были доложены результаты исследования III фазы, в котором сравнивалась эффективность комбинации ипилимумаба и дакарбазина с дакарбазином в монорежиме. Оказалось, что добавление ипилимумаба к химиотерапии дакарбазином приводит к увеличению продолжительности жизни (медиана общей выживаемости возросла с 9,1 до 11,2 мес). Кроме того, медиана длительности лечебных эффектов в группе ипилимумаб + дакарбазин более чем в 2 раза превосходила этот показатель в группе дакарбазин + плацебо.
Особенностью профиля токсичности препарата ипилимумаб является развитие так называемых иммуноопосредованных нежелательных явлений, среди которых преобладают: колит (иммунной природы), гепатит (аутоиммунный), гипофизит (с клиникой питуитарной недостаточности), адреналит. Разработаны достаточно эффективные способы выявления и устранения таких осложнений, что предусматривает отмену ипилимумаба, назначение глюкокротикостероидов, симптоматическую терапию.
В 2010 г. ипилимумаб был зарегистрирован в США как препарат выбора для лечения больных диссеминированной меланомой кожи. В 2011 г. ипилимумаб проходит регистрацию в Европе.
ТАРГЕТНАЯ ТЕРАПИЯ ИНГИБИТОРОМ BRAF-КИНАЗЫ проводится препаратом вемурафениб (zelboraf ™). Назначение вемурафениба может (более чем в 50% случаев) блокировать экспрессию мутировавшего гена BRAF V600E, что повышает эффективность лечения сравнительно со стандартной химиотерапией. Мутация V600E в гене BRAF, приводит к экспрессии измененной BRAF-киназы, которая активирует MAPK/ERK путь и, в итоге, вызывает неконтролируемую пролиферацию опухолевых клеток, блокаду апоптоза и активацию ангиогенеза. Данная мутация встречается у каждого второго больного меланомой кожи. Создание таргетных киназных ингибиторов позволило начать широкомасштабные клинические исследования препаратов, в которых мишенью для направленной терапии стала BRAF-киназа.
В международном многоцентровом открытом клиническом исследовании II фазы BRIM2 оценена эффективность вемурафениба у 132 больных распространенной меланомой, у которых подтверждена мутация BRAF V600E и которым ранее проводилась химиотерапия. Общая частота лечебных эффектов вемурафениба в этом исследовании составила 52%. В другом открытом международном рандомизированном контролируемом мультицентровом клиническом исследовании III фазы BRIM3 (2007) лечение проведено 675 больным распространенной меланомой, у которых была подтверждена мутация BRAF V600E и которым ранее не проводилась химиотерапия. Эффективность вемурафениба сравнивалась со стандартом химиотерапии меланомы – дакарбазином. Частота лечебных эффектов в группе вемурафениба составила 48,7% (1% полных и 47,7% частичных регрессиий), сравнительно с 5,5% частичных эффектов в группе химиотерапии дакарбазином (p<0,0001). Таргетная терапия увеличила медиану продолжительность жизни без прогрессирования (с 1,6 до 5,3 мес). Медиана общей выживаемости в группе химиотерапии составила 7,9 мес, а в группе вемурафениба еще не была достигнута на день анализа результатов исследования.
Среди наиболее частых побочных эффектов вемурафениба следует отметить высокую (30%) частоту развития плоскоклеточного рака кожи. Также отмечены аллергические реакции, фотосенсибилизация, увеличение интервала QT на ЭКГ, повышение уровня трансаминаз печени, артралгии, алопеция, кожная сыпь, утомляемость, и др. По результатам исследований BRIM2 и BRIM3 в августе 2011 г. вемурафениб одобрен в США для лечения больных распространенной меланомой кожи, у которых подтверждена мутация BRAF V600E.
ВАКЦИНОТЕРАПИЯ АУТОЛОГИЧНЫМИ ДЕНДРИТНЫМИ КЛЕТКАМИ.
Поскольку меланома кожи является иммуногенной опухолью, способной индуцировать Т-клеточный противоопухолевый иммунный ответ in vivo, в 2000-х гг. стали активно разрабатываться различные виды иммунотерапии. Одним из видов специфической иммунотерапии является вакцинотерапия дендритными клетками. Аутологичные дендритные клетки онкологического больного стимулируются опухолевыми антигенами in vitro и возвращаются пациенту с целью индукции противоопухолевого иммунного ответа. По данным многочисленных исследований I-II фазы клиническая эффективность дендритной вакцины при метастатической меланоме кожи может достигать 15-30%. Поскольку эффективность вакцины обратно пропорциональна распространенности процесса, результаты лечения лучше в начальных стадиях. Кроме того, метод представляется перспективным в плане адъювантной терапии после удаления опухоли.
По результатам клинического исследования I фазы, проведенного ранее в РОНЦ, показана безопасность и удовлетворительная переносимость вакцинотерапии дендритными клетками. Частота лечебных эффектов при метастатической меланоме кожи III и IV стадий, с локализацией очагов в мягких тканях и лимфатических узлах, составила 11,8%, что сопоставимо с 5-10% эффективностью дакарбазина – стандарта паллиативного лечения и к тому же обладающего более выраженной токсичностью. При вакцинотерапии меланомы III стадии медиана выживаемости составила 31 мес, а IV – 17 мес (что существенно превосходит данные исторического контроля, в которых, как известно, медиана общей выживаемости при IV стадии не превышала 6-9 мес).
В период с 2003 по 2008 гг. в РОНЦ проведено экспериментальное («pilot») исследование по изучению клинической и иммунологической эффективности аутологичной дендритной вакцины у 108 пациентов меланомой кожи III и IV стадий после радикального хирургического лечения. Лечебную группу составили 46 пациентов третьей и 10 − четвертой стадией заболевания. В контрольной группе эти стадии определены у 47 и 5 пациентов, соответственно. Средний возраст в анализированных группах соответствовал 52 и 53 годам, группы были сбалансированы по факторам, определявшим прогноз заболевания. Результаты исследования подтвердили целесообразность клинического применения дендритных вакцин в плане адъювантной терапии. Их введение с профилактической целью увеличивало медиану времени до прогрессирования с 4,8 до 10 мес, повышало показатели выживаемости: 1-летняя продолжительность жизни в контрольной и лечебной группах составила 83 и 85%; 3-летняя – 50 и 63% (p>0,05; logrank test).
Таким образом, прежние представления о бесперспектитвности лечения метастатической меланомы изменились. В клиническую практику внедряются перспективные методики – таргетная терапия (препараты ипилимумаб, вемурафениб), специфическая иммунотерапия (вакцинотерапия дендритными клетками). Это позволяет восстанавливать иммунный контроль над опухолью, дает возможность индивидуализировать подбор терапии. Лечебные разультаты определяют направления дальнейших исследований – изучение эффективности комбинаций новых препаратов, последовательности их применения, др.